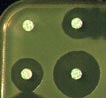

ANTIBIOTIQUES IV : ETUDES IN VITRO, L'ANTIBIOGRAMME
A - INTRODUCTION
Malheureusement certaines espèces bactériennes peuvent s'adapter plus rapidement aux antibiotiques (résistance acquise) et donc, être classées en "inconstamment sensible" à tel ou tel antibiotique, ce qui nécessitera d'effectuer au laboratoire, un antibiogramme.
La résistance acquise des bactéries a toujours été préoccupante et a justifié de préciser des règles de prescription.
B - DÉFINITION DE L'ANTIBIOGRAMME :
C'est la détermination de la sensibilité d'une bactérie aux antibiotiques. Terme contracté par analogie avec l'hémogramme. Examen quotidien de laboratoire, en particulier hospitalier pas toujours nécessaire (cf classes thérapeutiques)
C - INTÉRÊT DE L'ANTIBIOGRAMME
Cet examen de routine va permettre de comparer la valeur de la CMI d'un antibiotique par rapport à celle de deux concentrations critiques c et C (mg/l). Il permet de catégoriser la souche à étudier en confrontant la CMI d'un antibiotique donné à celle de la concentration c ou C, proposée par le Comoté d'experts, en France CA-SFM, Comité de l'Antibiogramme de la Société Française de Microbiologie).
A - INTRODUCTION
|
Il n'est pas toujours nécessaire de rechercher la sensibilité d'une bactérie à un antibiotique. Car ce type de traitement est bien standardisé dans certaines infections et les espèces bactériennes impliquées sont restées toujours sensibles à cet ou ces antibiotiques: classe thérapeutique "habituellement sensible" et "modérément sensible".
|
 |
La résistance acquise des bactéries a toujours été préoccupante et a justifié de préciser des règles de prescription.
| Objectifs d'aujourd'hui Est-il toujours nécessaire de demander un antibiogramme ? Quelle définition de l'antibiogramme pourriez-vous donner ? Etes-vous capable de définir la CMI ? Pouvez-vous décrire succintement les diverses méthodes de détermination de la CMI ? Comment partant d'un diamètre d'inhibition autour d'un disque d'antibiotique, peut-on obtenir la CMI ? Comment à partir de la CMI, peut-on catégoriser en S, I, ou R ? |
B - DÉFINITION DE L'ANTIBIOGRAMME :
C'est la détermination de la sensibilité d'une bactérie aux antibiotiques. Terme contracté par analogie avec l'hémogramme. Examen quotidien de laboratoire, en particulier hospitalier pas toujours nécessaire (cf classes thérapeutiques)
C - INTÉRÊT DE L'ANTIBIOGRAMME
Cet examen de routine va permettre de comparer la valeur de la CMI d'un antibiotique par rapport à celle de deux concentrations critiques c et C (mg/l). Il permet de catégoriser la souche à étudier en confrontant la CMI d'un antibiotique donné à celle de la concentration c ou C, proposée par le Comoté d'experts, en France CA-SFM, Comité de l'Antibiogramme de la Société Française de Microbiologie).

| - La méthode de dilution en milieu liquide consiste à préparer une série de vue à hémolyseavec le même milieu de culture liquide (deux ml) puis constituer une gamme de concentrations de l'antibiotique à tester, par exemple 0,5 mg/l 1, 2, 4, 8, 16 (raison géométrique de base 2). |
 |
Le principal inconvénient de cette méthode est la quantité de tubes à manipuler, soit 100 tubes pour une dizaine d'antibiotiques à examiner.
- Une variante de cette méthode consiste à utliiser des microcupules en plaque au lieu de tubes. Il s'agit d'une microméthode en milieu liquide.
Voici un exemple avec indicateur de pH

- Certains dispositifs commerciaux utilisent ce type de variante, par exemple pour la détermination de la CMI d'une ß-lactamine chez une souche de Streptococcus pneumoniae.

| - La méthode de dilution en milieu solide consiste à incorporer l'antibiotique à une concentration donnée dans la gélose, maintenue liquide à 42°C. Une série de boites de Pétri est préparée avec des concentrations d'antibiotique variant selon une progression géométrique de base de 2, comme précédemment. |  |
| Des tiges métalliques stériles plongent dans chaque cupule. Puis par un mouvement de translation sont déposées les différentes bactéries sous le même volume (de l'ordre du microlitre) à la surface du milieu gélosé ou solide. |
 |
| Après avoir ensemencer la série de boîtes, celles-ci sont incubées dans une étuve jusqu'au lendemain. La lecture est alors effectuée: il est facile de repérer l'emplacement de chaque souche et de noter croissance ou absence de croissance. |
 |
Cette méthode semi-automatique permet d'examiner des séries de 20 souches à 98 souches selon le type de plaque.Cette méthode de détermination de la CMI par une approche directe est , en fait, peu pratique.Car tester la sensibilité à 10 antibiotiques nécessite de préparer une centaine de boîtes contenant les diverses concentrations d'antibiotique.
- La méthode de diffusion ou des disques en milieu solide est la plus simple. Elle consiste à ensemencer en surface d'un milieu solide par inondation de la souche à tester. Puis à déposer des disques de papier buvard comprenant un antibiotique à une certaine concentration.
 |
 |
 |
|
Après solubilisation de l'antibiotique par l'humidité du milieu gélosé, il s'établit un gradient de concentration qui varie avec le temps.
|
 |
|
La boite ainsi préparée est mise à incuber pendant une nuit à 37°C. Il est possible de voir la croissance bactérienne (au milieu de la boite) ainsi que des zones d'inhibition de la croissance circulaires, à proximité de chaque disque.
|
Plus la zone d'inhibition est grande, plus grande est la sensibilité de la souche bactérienne testée vis-à-vis de l'antibiotique étudié. Chaque zone peut être mesurée selon divers moyens: règle, compas, pied à coulisse.....
 |
Lecture automatique avec une caméra
 |
La zone d'inhibition circulaire est mesurée par le diamètre en mm, puis il sera possible de calculer la CMI de l'antibiotique pour la souche examinée en reportant ce diamètre sur une courbe de concordance, pré-établie à l'avance avec une centaine de souches (échantillonnage) de sensibilités différentes.

Connaissant le diamètre d'inhibition pour un antibiotique donné, je puis déterminer la CMi (mg/l) d'un antibiotique pour une souche bactérienne.

 |
Néanmoins la détermination par cette méthode est insatisfaisante, d'où la nécessité de recourir à la méthode directe par dilution ou encore à d'autres méthodes comme celle du E-test. |
|
- D'autres méthodes dont certaines semi-automatiques ont été proposées depuis une vingatine d'années.
|
 |
|
||
 |
 |
 |
| - Nouvelle génération d'automates mais méthode un peu plus lente en 6 -10 heures : |
||
 |
 |
|
E - CONCLUSION
Prescrire un examen cyto-bactériologique et un antibiogramme est un acte quotidien et banal qui va rechercher à confirmer la sensibilité d'une bactérie à un antibiotique donné. Néanmoins cet examen routinier n'explore pas les intereactions entre deux, voire trois antibiotiques sauf circonstances particulières comme montré ci-dessous.
 |
 |
D'autres méthodes permettent de préciser d'autres paramètres d'une antibiothérapie adaptée comme de calculer les effets synergiques de deux antibiotiques tel l'effet bactériostatique et bactéricide d'une assocation de deux antibiotiques ou encore le pouvoir bactéricide du sérum (cf travaux pratiques).
 |
 |
Ce cours a été préparé par le Professeur A. PHILIPPON (Faculté de Médecine COCHIN-PORT-ROYAL, Université PARIS V)
Pour en savoir plus:

![]() Validation de vos connaissances
Validation de vos connaissances
|
|
|
|
|
